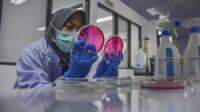
Pengujian Kandungan Kimia pada Produk UMKM

KOTA TANGERANG, LENSABANTEN.CO.ID — Asosiasi Pengusaha Jasa Boga Indonesia (APJI) Kota Tangerang membuka peluang bagi […]
KOTA TANGERANG, LENSABANTEN.CO.ID -- Asosiasi Pengusaha Jasa Boga Indonesia (APJI) Kota Tangerang membuka peluang bagi […]
Lensa Headlines
Lensa Headlines
Tag: UMKM kota tangerang
Sandal Minimax Asal Cipondoh Kembali Tampil di Inacraft 2026
KOTA TANGERANG, LENSABANTEN.CO.ID — Produk sandal Minimax asal Kecamatan Cipondoh, Kota Tangerang, kembali menembus pasar […]
Tembus Pasar Korea Selatan, UMKM Rotan Indonesia Raup Omzet Rp121 Juta di Seoul Design Festival 2025
KOREA SELATAN, LENSABANTEN.CO.ID — Pelaku UMKM kriya rotan Indonesia, ROKA Collection, menorehkan capaian positif dalam […]
FOTO : Menteri UMKM Target 2,1 juta Usaha Mikro Naik Kelas pada 2029
Perajin merapihkan aksesoris kalung di Diftria Art Crafting, Kecamatan Cipondoh, Kota Tangerang, Banten, Kamis (23/10/2025).Kementerian […]
UMKM Asal Tangerang Tembus Pasar Afrika Lewat Trade Expo Indonesia 2025
TANGSEL, LENSABANTEN.CO.ID — Pameran Trade Expo Indonesia (TEI) ke-40 tahun 2025 kembali digelar di ICE […]
Disperindagkop Tangerang Perkuat UMKM Lewat Bimtek Entrepreneur Hub
KOTA TANGERANG, LENSABANTEN.CO.ID — Untuk memperkuat ekosistem pelaku usaha mikro, kecil, dan menengah (UMKM), Dinas […]
UMKM Cibodas Jasa Manfaatkan Teknologi untuk Tingkatkan Omset
KOTA TANGERANG, LENSABANTEN.CO.ID — Gerai usaha mikro kecil menengah (UMKM) Cibodas Jasa di kecamatan Cibodas […]
UMKM Batik Umi Aiman Meriahkan Tangerang Great Sale
KOTA TANGERANG, LENSABANTEN.CO.ID – Tangerang Great Sale kali ini diramaikan oleh berbagai pelaku UMKM Kota […]
FOTO : Pengujian Kandungan Kimia pada Produk UMKM
Petugas melakukan pengujIan kandungan zat kimia pada produk UMKM di Laboratorium Kesehatan Daerah (Labkesda) Kota […]
Indomaret Ajari Ratusan UMKM Tangerang Ciptakan Produk Unggul
KOTA TANGERANG, LENSABANTEN.CO.ID – Wali Kota Tangerang, Arief R. Wismansyah, telah meminta Indomaret untuk menjadi […]
Tidak Ada Pos Lagi.
Tidak ada laman yang di load.